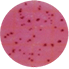
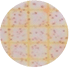
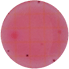
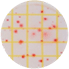
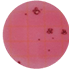
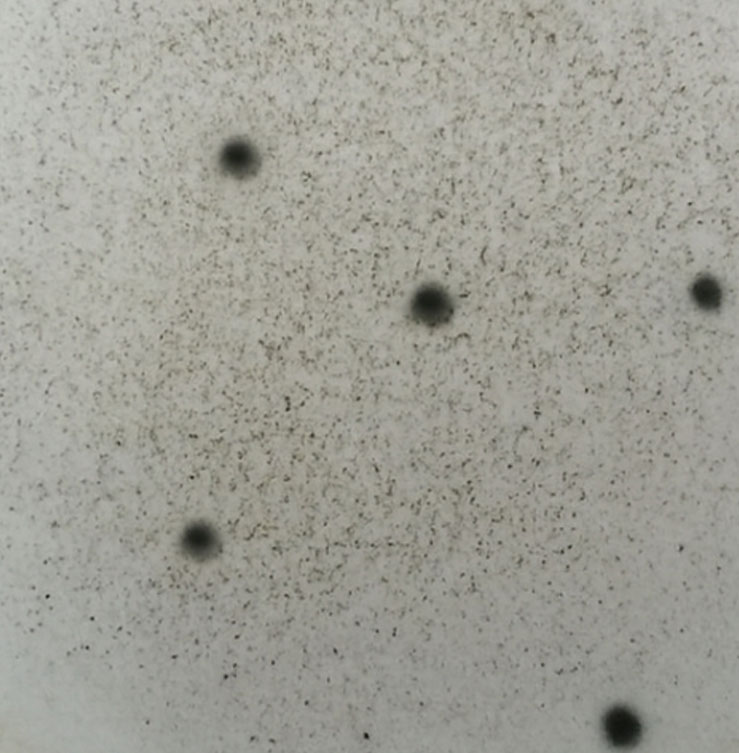
녹차진균 비살균

CBST 복합살균공법이란?
수년간 자체 연구개발한 독자적인 분말 살균 공법
공법 소개
- CBST 복합살균공법은 수년간 자사에서 연구개발한 복합살균공법(CBST)을 지칭하며, 유해균으로부터 안전한 식품원료를 의미합니다.
- 영양분 파괴와 변형을 최소화하였으며, 화학적 또는 고온살균방식이 아닌 친환경 살균공법으로 사용자 중심의 안전한 식품원료를 공급하고 있습니다.
- 자체 개발한 Microwave 살균장치를 이용한 복합살균공법으로, 조사(방사선)살균이나 화학적 살균방식이 아닌 친환경 공법입니다.
CBST 복합살균이 왜 필요한가?


-
- 식품의 부패 변질 방지
- 신선도 유지
- 맛의 변질 방지
- 영양분 유지
- 저장 기간 UP
-
- 식품의 가장 중요한 조건
- 유해세균 및 바이러스 제거
- 완제품 오염 방지
- 식중독 등 예방
- 식품에 대한 불안감 해소
-
- 살균은 선택이 아닌 필수
- 화학물질을 이용한 살균 방식 대체
- 방사선조사 살균 방식 대체
- 친환경적 생산방식
더원네이처 살균원료의 특징
자체개발한 Microwave 복합살균장치를 이용한 안전한 공법
비조사
조사(방사선) 살균 처리를 하지 않았습니다.
대량생산
대량생산과 최소 10kg 이상 대량포장이 가능합니다.
친환경
인체에 유해한 화학물질을 사용하지 않았습니다.
비파괴
영양분 파괴를 최소화합니다.
자체 개발한 Microwave 살균장치
자체개발한 MICRO WAVE 복합살균장치를 이용한 살균공법으로 조사(방사선)살균이나 화학적 살균방식이 아닌 친환경 살균공법으로 보다 안전하고 믿을 수 있는 식품원료를 공급하고 있습니다.
더원네이처의 살균은 어떻게 이루어지나요?

식품원료는 입고부터 생산을 거쳐 출고에 이르는 전 과정에 있어 오염이 발생할 수 있습니다.
더원네이처는 각 공정마다 오염 환경을 연구하고 테스트하여 최적의 복합살균공법(CBST)을 개발하여 적용하였습니다.
병원성 진균 검출 사례
※ 일부 발효혼합곡물 제품에서 병원성 진균이 검출된 사례가 확인되었습니다.

- 외부기관 시험성적서 결과에 따라 분말 원료의 위생 관리 중요성이 확인되었습니다.
- 병원성 진균은 적절한 살균 공정을 적용할 경우 효과적으로 감소 및 제어가 가능합니다.
- 완제품의 안전성과 품질 확보를 위해 원료 단계에서의 체계적인 분말 살균 공정이 필수적입니다.
- 진균 및 병원성 진균은 원료의 재배·수확·건조·보관 과정에서 외부 환경 요인에 의해 발생할 수 있습니다.
- 특히 오염된 원료나 위생 관리가 미흡한 생산 환경, 비살균 제품에서는 병원성 진균, 대장균 등 유해 미생물이 검출될 가능성이 존재합니다.
- 이러한 미생물 오염을 예방하기 위해 원료 단계에서의 선제적이고 체계적인 살균 관리가 중요합니다.
CBST 복합살균공법 살균 결과
대장균(군), 병원성 진균 등 다양한 유해균들의 완전 살균을 목표로 하고 있으며, 일반 세균 수는 0~1,000마리 수준까지 관리하고 있습니다.
← 좌우로 스크롤하세요 →
| 검사 항목 | 분말상태(색상) | 대장균, 대장균군 | 병원성 진균(일반세균) | |||
|---|---|---|---|---|---|---|
| 비살균 | 살균 | 비살균 | 살균 | 비살균 | 살균 | |
| 대추 분말 |  |
 |
 |
 |
 |
 |
| 흑임자 분말 |  |
 |
|
 |
|
 |
| 돼지감자 분말 |  |
 |
 |
 |
 |
 |
| 마늘 분말 |  |
 |
|
 |
|
 |
| 멸치 분말 |  |
 |
|
 |
 |
 |
| 비트 분말 |  |
 |
 |
 |
 |
 |
외부 오염방지를 위한 살균 포장
살균 포장 규격 사이즈

- 기본 포장단위: 10kg ~ 15kg
- 최종 포장방식
1차 – 살균 포장(PE재질)
2차 – 종이박스
시험검사성적서


살균 성적서
자가품질검사서

외부기관성적서

[살균 전 대장균군 양성]

[살균 후 대장균군 음성]
CBST+ 프리미엄살균이란?
원료 특성 보존에 최적화된 프리미엄 살균 공정
CBST+ 프리미엄살균공법 소개
CBST+ 살균은 원료 고유의 색상과 유효 성분 변화를 최소화하도록 설계된 프리미엄 분말 살균 공정으로, 원료 특성을 최대한 보존하는 데 중점을 둔 기술입니다.
CBST 복합살균공법 vs CBST+ 프리미엄살균공법
원료 특성과 제품 용도에 따라 CBST 복합살균공법과 CBST+ 프리미엄살균공법을 선택하여 적용할 수 있습니다.
| 구분 | CBST 복합살균공법 | CBST+ 프리미엄살균공법 |
|---|---|---|
| 공정 수준 |
복합살균공법
|
프리미엄 살균공법
|
| 특징 |
안정적인 살균과 품질 관리
|
색상·성분 변화 최소화 강화
|
| 장점 |
철저한 미생물 제어
|
원료 고유 특성 보존력 향상
|
| 적합 제품 |
환 · 정 · 캡슐 · 스틱용 원료 분말
|
색상 보존이 중요한 원료
|
병원성 진균 검출 사례
※ 일부 발효혼합곡물 제품에서 병원성 진균이 검출된 사례가 확인되었습니다.

- 외부기관 시험성적서 결과에 따라 분말 원료의 위생 관리 중요성이 확인되었습니다.
- 병원성 진균은 적절한 살균 공정을 적용할 경우 효과적으로 감소 및 제어가 가능합니다.
- 완제품의 안전성과 품질 확보를 위해 원료 단계에서의 체계적인 분말 살균 공정이 필수적입니다.
- 진균 및 병원성 진균은 원료의 재배·수확·건조·보관 과정에서 외부 환경 요인에 의해 발생할 수 있습니다.
- 특히 오염된 원료나 위생 관리가 미흡한 생산 환경, 비살균 제품에서는 병원성 진균, 대장균 등 유해 미생물이 검출될 가능성이 존재합니다.
- 이러한 미생물 오염을 예방하기 위해 원료 단계에서의 선제적이고 체계적인 살균 관리가 중요합니다.
녹차 CBST+ 살균 결과
대장균(군), 병원성 진균 등 다양한 유해 미생물의 제어를 목표로 하며, 원료의 색상 변화를 최소화하도록 관리합니다.
← 좌우로 스크롤하세요 →
| 검사 항목 | 색상 변화 | 대장균(군) | 병원성 진균 | |||
|---|---|---|---|---|---|---|
| 비살균 | 살균 | 비살균 | 살균 | 비살균 | 살균 | |
| 녹차 |  |
 |
 |
 |
|
 |
※ 시험 조건 및 원료 로트에 따라 결과는 달라질 수 있습니다.
녹차 CBST+ 살균 전·후 성분 분석 결과
녹차 원료 기준, 영양성분 및 대표지표성분(카테킨) 전·후 비교
영양성분 보존
11개 항목 분석CBST+ 살균 후에도 주요 영양성분 변화가 거의 없이 안정적으로 유지되었습니다.
| 구분 | 살균 전 비살균 |
살균 후 CBST+ |
변화 |
|---|---|---|---|
| 열량(kcal/100g) | 390.24 | 390.84 | 변화미미 |
| 탄수화물(g/100g) | 69.27 | 69.11 | 변화미미 |
| 당류(g/100g) | 4.03 | 4.01 | 변화미미 |
| 조단백질(g/100g) | 19.47 | 19.60 | 변화미미 |
| 조지방(g/100g) | 3.92 | 4 | 변화미미 |
| 포화지방(g/100g) | 0.31 | 0.32 | 변화미미 |
| 트랜스지방(g/100g) | 0 | 0 | 유지 |
| 콜레스테롤(mg/100g) | 0 | 0 | 유지 |
| 나트륨(mg/100g) | 4.51 | 5.13 | 변화미미 |
| 수분(%) | 2.05 | 2.11 | 변화미미 |
| 회분(%) | 5.29 | 5.18 | 변화미미 |
※ 시험기관 : 한국기능식품연구원 | 시험 조건 및 로트에 따라 결과는 다를 수 있습니다.
카테킨 함량 보존
대표 지표성분살균 공정 이후에도 유효 성분인 카테킨 함량이 안정적으로 유지됨을 확인하였습니다.
| 구분 | 살균 전 비살균 |
살균 후 CBST+ |
변화 |
|---|---|---|---|
| 카테킨 함량(mg/g) | 90.10 | 90.34 | 변화미미 |
※ 시험기관 : 한국기능식품연구원 | 시험 조건 및 로트에 따라 결과는 다를 수 있습니다.
🍵 카테킨이란?
카테킨은 녹차의 대표적인 기능성 지표 성분으로, 항산화·항균 효능이 뛰어난 폴리페놀 화합물입니다. CBST+ 살균 후에도 거의 동일한 수준(90.10 → 90.34 mg/g)으로 유지되어 살균이 유효성분에 영향을 미치지 않음을 확인하였습니다.





